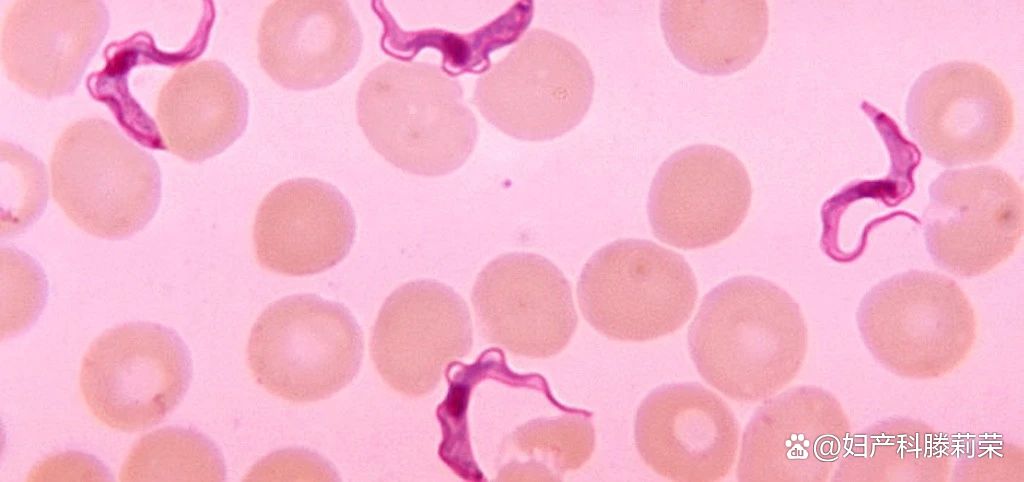
体检中发现HPV阳性，是得性病了吗？

HPV(全称人乳头瘤病毒)是一种非常常见和广泛分布的病毒。目前,科学家已经确定了170多个亚型,隶属于16个属,其中5个属与人类有关。我们=皮肤科医生最关心的是粘膜型(α)和皮肤型(β),这是我们讨论的范畴。前者引起口腔和肛门外生殖部位的疣,后者引起寻常疣、足底疣、扁平疣等非典型良性皮肤增生。

根据其致病性及是否与肿瘤相关,可将α-HPV分为低危型和高危型。至少有5种低风险类型,即HPV 6、11、42、43、44,至少有13种高风险类型,即16、18、31、33、35、39、45、51、52、56、58。肛生殖器尖锐湿疣90%是由低风险的6型和11型引起的,其中HPV 6型较为常见。说到女性的HPV变色,16型和18型HPV是85%以上宫颈癌的罪魁祸首。
感染HPV是性病吗?
感染HPV不是一种性传播疾病,但由HPV感染引起的尖锐湿疣是一种性传播疾病,是发病率最高的性传播疾病之一,且仍在上升。然而,并不是所有尖锐湿疣都是通过性传播的,有些人因为外阴和肛门周围的皮炎和湿疹而长期感染。近年来,我们注意到越来越多的婴幼儿患有尖锐湿疣,而且大多不是通过性接触传播的。
我为什么会感染HPV?
记住,HPV非常常见,就像感冒病毒一样无处不在。几乎所有的男人和女人都会在一生中的某个时刻被感染。毫无疑问,不洁的*行为性**是传播HPV病毒的经典方式。如果你和你的伴侣对自己问心无愧,那么没人知道你是怎么感染的,问医生也不会给你答案。但大多数时候,感染HPV并不是什么大问题。它通常会自己消失。大多数人甚至不知道他们已经感染了HPV,他们只在体检中发现。
HPV是如何被检测到的?
HPV非常特殊,它只潜入皮肤和粘膜,而不进入血液,所以不能被血液检测到。潜伏型HPV感染不会引起任何临床表现和组织学异常,只有通过严格的实验室检查,才能在皮肤黏膜脱落细胞中检测到病毒DNA。如果出现皮疹,检出率会大大提高。然而,并不是所有尖锐湿疣患者都能检测出HPV病毒。相反,当在正常皮肤上检测到HPV病毒时,不能诊断为“尖锐湿疣”。
在妇科检查中,有一种筛查HPV感染的方法叫做巴氏涂片。在检查过程中,从宫颈轻轻刮取细胞,并在显微镜下检查是否有发育不良的迹象,如果有,产科医生和妇科医生会建议进一步检查。
HPV感染后的表现如何?
潜伏型HPV感染和亚临床感染没有症状,长出皮疹时称为“尖锐湿疣”。刚开始的时候,是一个非常小的淡红色或肤色的痘痘,只有用放大镜和醋美白试验才能观察到。此时,没有疼痛、瘙痒或异物感。逐渐增大,变成乳头状、花椰菜状、鸡冠状,有些融合成地毯状。这时可能出现瘙痒、分泌物增多、臭味和异物感。尿道大疹可引起排尿改变,肛门管大的疣可引起排便困难和出血。免疫力差,皮疹迅速增加;免疫力强的人可能只会有一点皮疹,而且可能会自行消退。

另一种与粘膜高危HPV感染相关的皮肤病叫做鲍恩样丘疹病,其生长像地毯一样,表面光滑或丝绒状,伴有黑色素沉积,斑点大如米粒和豆子,可并发尖锐湿疣。组织学上,鲍恩样丘疹病侵入皮肤更深,因此,在治疗中更容易复发。
如果我感染了人乳头瘤病毒,应该怎样做?
如果没有症状,HPV被归类为低风险类型,不需要治疗。每2-3个月请皮肤科医生做一次常规检查,半年后如无异常应停止检查。如果女性宫颈发现hpv阳性,请咨询妇科医生,可能需要阴道镜活检。如果已经长出疣,就去看皮肤科医生,不要在网上购买药品/保健品。高危的HPV在变成癌症之前通常很容易治疗,这就是为什么定期对女性进行HPV检测是如此重要,尤其是那些有感染史和家族史的女性。
尖锐湿疣的潜伏期有多长?
尖锐湿疣的潜伏期从半个月到八个月不等,平均2-3个月。
如果你感染了HPV,必须跟伴侣坦白吗?
感染HPV意味着你接触了一种常见的病毒,是一种不明原因感染的病毒,这并不能反映你自己、你的性格或你的价值观。你可以跟你的伴侣说出真相,你不必道歉或感到内疚。如果疣已经长出来了,更明智的做法是告诉你的伴侣关于你的真实情况,和她(他)一起去医院检查,因为诚实和透明对人际关系有着广泛而长期的影响。
